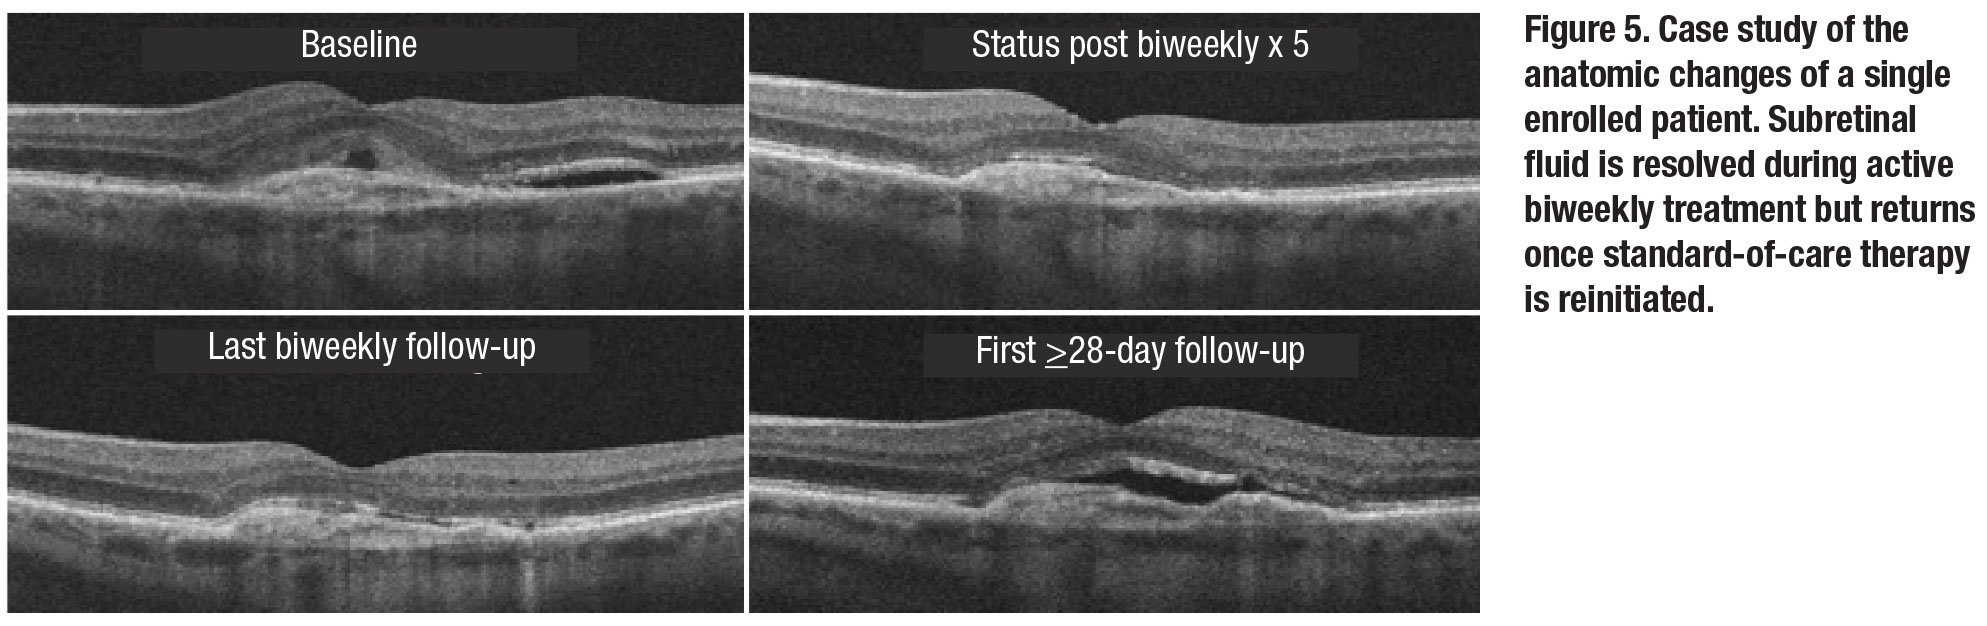

![]() |
![]() |
The original treatment paradigm for neovascular age-related macular degeneration relied on repeated monthly dosing of anti-VEGF agents to achieve optimal visual gain and anatomic resolution of intra- or subretinal fluid on optical coherence tomography imaging.
With the introduction of variable dosing regimens such as “PRN” (pro re nata) and “treat-and-extend,” patients demonstrating a good response to anti-VEGF therapy can be treated at extended intervals after achieving specific benchmarks, most often resolution of fluid on OCT.1,2
A matter of definition
• Refractory/treatment-resistant nAMD. However, patients who don’t meet these benchmarks cannot be extended. They fall into a somewhat ill-defined refractory or treatment-resistant category. The term refractory nAMD remains largely fluid in its definition, because it hasn’t been constrained to one specific time frame or criteria. Rather, the term is applied to a wide range of findings; the foundation is treatment resistance despite aggressive therapy over an extended period of time.3
Some classification systems look to define treatment-resistance as persistent exudation on retinal imaging; others require three or more lines of Snellen acuity loss.4 In the absence of a consensus, many consider more than 12 months of persistent exudation found on OCT, despite monthly anti-VEGF therapy, to be indicative of treatment-resistant nAMD.5,6
Using this latter definition, the size of the refractory nAMD problem comes into view. One-year CATT data demonstrated persistent fluid on OCT despite 12 monthly treatments in 53.2 percent of ranibizumab-treated and 70.9 percent of bevacizumab-treated patients (Lucentis and Avastin, Genentech/Roche). In the VIEW 1 and 2 studies, 27.6 percent of patients had intra- or subretinal fluid (IRF, SRF) after 12 monthly aflibercept injections (Eylea, Regeneron Pharmaceuticals).7,8 Given the prevalence of this problem, an assessment of treatment options for this challenging population appears warranted.
![]() |
Anti-VEGF-based approaches
• Switching anti-VEGF agents. With the proliferation of new anti-VEGF agents, one of the simplest approaches to refractory disease is to switch to a different agent. Various logic has been applied to this approach, from combating theoretical tachyphylaxis to taking advantage of improved binding affinity or superior intravitreal pharmacokinetics.9-11
Following the release of aflibercept in 2012, numerous small retrospective studies detailed results of treating nAMD refractory to ranibizumab or bevacizumab with aflibercept.12,13 Although such small retrospective studies are inherently difficult to interpret, subsequent meta-analyses reported significantly improved anatomic, though not visual, outcomes following a switch to aflibercept.14,15
• Increasing anti-VEGF dose. Investigators have also explored the use of larger anti-VEGF doses as a way to boost efficacy via greater binding site availability. The HARBOR study, which compared ranibizumab 2 mg monthly or PRN to the standard 0.5-mg dose monthly or PRN, found no statistically significant difference in visual or anatomic outcomes in treatment-naïve patients.7 The subsequent LAST and SAVE studies in “treatment-resistant” populations, however, did show modest visual and anatomical improvements at six months when switching resistant patients from monthly 0.5-mg to 2-mg ranibizumab.16,17
![]() |
• Increasing anti-VEGF dosing frequency. Similar to increasing the dose of the anti-VEGF agent, increasing the dosing frequency achieves the goal of delivering greater amounts of anti-VEGF binding capacity into the eye. Based on mathematical modeling of time-
related binding activities of the various
anti-VEGF agents, however, increased dosing frequency (q2 weeks) provides much greater trough levels of drug compared to an increased dose (Figure 1, page 27).18 Given the vast excess of anti-VEGF binding activity at peak levels (e.g., immediately following injection), trough-binding activity likely dictates efficacy.
Further support for increased dosing frequency can be obtained from examination of serial OCT angiography data looking at the choroidal neovascular membrane's response to anti-VEGF therapy. Following anti-VEGF treatment, a maximum decrease in choroidal neovascular dimension and microvascular rarefaction has been seen at 12 to 18 days, with resultant reproliferation noted thereafter.19
![]() |
Two small retrospective studies examined the utility of a short course (three to four doses) of biweekly anti-VEGF therapy for refractory nAMD, with mixed results. An Israeli study didn’t find any significant anatomic or visual improvement, with about one quarter of patients demonstrating morphologic improvement.20 In contrast, Andre Witkin, MD, and colleagues reported that they achieved significant visual-acuity gains and central foveal thickness benefits.21
![]() |
Increased frequency: A deeper dive
In light of the strong rationale for increased dosing frequency and limited available data in the literature, our group designed a retrospective study to analyze outcomes of patients within our practice who had received biweekly anti-VEGF therapy for refractory nAMD. For purposes of this study, we defined refractory nAMD as persistent IRF/SRF observed on spectral-domain OCT following six or more monthly (q28 to 35 days) anti-VEGF injections.
Participating patients had to have received five or more consecutive biweekly anti-VEGF injections (every 12 to 21 days) with a two-week follow-up visit after the fifth biweekly injection and a minimum of 12 months of follow-up after initiation of biweekly therapy. The primary endpoint was two weeks after the fifth consecutive biweekly injection (visit six). In order to assess the impact of a return to standard of care (SoC) monthly dosing, we also reassessed outcomes at both the final biweekly and first monthly (≥28 day) follow-up visits (Figure 2).
The 18 patients included in this analysis were representative of a chronic refractory nAMD population, with a mean duration of anti-VEGF therapy of 35.4 months. At baseline, five of 18 (27.8 percent) had persistent IRF while 16 of 18 (88.9 percent) had persistent SRF despite a mean inter-treatment interval of 30.9 days over the last three SoC injections.
In terms of biweekly treatment, patients underwent a mean of 18.1 biweekly injections at a mean treatment interval of 16.5 days. Figure 3 (page 28) shows the various
anti-VEGF agent combinations used prior to and during biweekly therapy.
Results of biweekly therapy
No safety signals were noted during biweekly therapy. From an anatomic standpoint, a significant decrease in central subfield thickness and cube volume was noted at visit six. Both measures remained significantly improved through the final biweekly visit, but only cube volume remained significantly improved upon return to SOC dosing (Figure 4).
Analysis of qualitative fluid status revealed biweekly therapy was more effective at eliminating SRF than IRF. Nearly one-third of patients had complete SRF resolution at visit six, while none achieved completed IRF resolution. This effect on SRF waned upon return to SOC dosing. Figure 5 demonstrates the anatomical response of a single included patient to biweekly therapy and highlights the return of SRF upon return to SoC dosing.
Overall, functional improvement was more limited. There was a significant improvement in best-corrected visual acuity at visit six compared to baseline. However, this was not sustained at the final biweekly or first SOC visit.
This study has several limitations, including its small size, retrospective design, heterogeneous biweekly dosing duration/anti-VEGF agent utilization and nonstandard follow-up timing.
Bottom line
The data from our study, as well as that presented by Dr. Witkin and colleagues and the Israeli researchers, suggest improved anatomic and possibly visual outcomes with increased dosing frequency in patients with refractory nAMD.
As noted, these retrospective studies have inherent limitations, particularly related to defining refractory patients in a post-hoc fashion, thus limiting the conclusions that can be drawn. In view of the prevalence of the problem and the limited data available, there appears to be a clear need for a prospective evaluation of increased anti-VEGF dosing frequency.
![]() |
Trial of biweekly aflibercept
To that end, we undertook an open-label prospective trial of biweekly aflibercept for patients with refractory nAMD. This study defined refractory nAMD as persistent SRF with or without IRF despite five or more monthly aflibercept injections in patients who have had a year or more of monthly anti-VEGF therapy.
In this trial, entitled TRISTAR (for Two-week Retreatment Interval Study for Treated AMD Refractory to monthly aflibercept), patients received six biweekly aflibercept injections with a secondary randomization into standard monthly therapy vs. four additional biweekly treatments for those with persistent SRF following the initial six biweekly treatments. Regeneron Pharmaceuticals is collaborating on the study.
The study enrolled 22 patients with the last patient/last visit in November 2019. The data are currently being analyzed with a plan to present the results at an upcoming meeting. It’s our hope that these data can clarify the utility of increased anti-VEGF dosing frequency in this challenging patient population. RS
![]() |
REFERENCES
1. Fung AE, Lalwani GA, Rosenfeld PJ, et al. An optical coherence tomography-guided, variable dosing regimen with intravitreal ranibizumab (Lucentis) for neovascular age-related macular degeneration. Am J ophthalmol. 2007;143:566-583.
2. Engelbert M, Zweifel SA, Freund KB. Long-term follow-up for type 1 (subretinal pigment epithelium) neovascularization using a modified "treat and extend" dosing regimen of intravitreal antivascular endothelial growth factor therapy. Retina. 2010;30:1368-1375.
3. Schachat AP. Switching anti-vascular endothelial growth factor therapy for neovascular age-related macular degeneration. Am J Ophthalmol. 2013;156:1-2.e1.
4. Broadhead GK, Hong T, Chang AA. Treating the untreatable patient: current options for the management of treatment-resistant neovascular age-related macular degeneration. Acta Ophthalmol. 2014;92:713-723.
5. Chang AA, Li H, Broadhead GK, et al. Intravitreal aflibercept for treatment-resistant neovascular age-related macular degeneration. Ophthalmology. 2014;121:188-192.
6. Kumar N, Marsiglia M, Mrejen S, et al. Visual and anatomical outcomes of intravitreal aflibercept in eyes with persistent subfoveal fluid despite previous treatments with ranibizumab in patients with neovascular age-related macular degeneration. Retina. 2013;33:1605-1612.
7. Ho AC, Busbee BG, Regillo CD, et al. Twenty-four-month efficacy and safety of 0.5 mg or 2.0 mg ranibizumab in patients with subfoveal neovascular age-related macular degeneration. Ophthalmology. 2014;121:2181-2192.
8. Jaffe GJ, Ying GS, Toth CA, et al, for the Comparison of Age-related Macular Degeneration Treatments Trials Research Group. Macular morphology and visual acuity in year five of the Comparison of Age-related Macular Degeneration Treatments Trials. Ophthalmology. 2019;126:252-260.
9. Schaal S, Kaplan HJ, Tezel TH. Is there tachyphylaxis to intravitreal anti-vascular endothelial growth factor pharmacotherapy in age-related macular degeneration? Ophthalmology. 2008;115:2199-2205.
10. Gasperini JL, Fawzi AA, Khondkaryan A, et al. Bevacizumab and ranibizumab tachyphylaxis in the treatment of choroidal neovascularisation. Br J Ophthalmol. 2012;96:14-20.
11. Lazzeri S, Ripandelli G, Sartini MS, et al. Aflibercept administration in neovascular age-related macular degeneration refractory to previous anti-vascular endothelial growth factor drugs: a critical review and new possible approaches to move forward. Angiogenesis. 2015;18:397-432.
12. Bakall B, Folk JC, Boldt HC, et al. Aflibercept therapy for exudative age-related macular degeneration resistant to bevacizumab and ranibizumab. Am J ophthalmol. 2013;156:15-22.e11.
13. Yonekawa Y, Andreoli C, Miller JB, et al. Conversion to aflibercept for chronic refractory or recurrent neovascular age-related macular degeneration. Am J Ophthalmol. 2013;156:29-35.e22.
14. Spooner K, Hong T, Wijeyakumar W, Chang AA. Switching to aflibercept among patients with treatment-resistant neovascular age-related macular degeneration: a systematic review with meta-analysis. Clin Ophthalmol. 2017;11:161-177.
15. Seguin-Greenstein S, Lightman S, Tomkins-Netzer O. A meta-analysis of studies evaluating visual and anatomical outcomes in patients with treatment resistant neovascular age-related macular degeneration following switching to treatment with aflibercept. J Ophthalmol. Published online March 6, 2016.
16. Fung AT, Kumar N, Vance SK, et al. Pilot study to evaluate the role of high-dose ranibizumab 2.0 mg in the management of neovascular age-related macular degeneration in patients with persistent/recurrent macular fluid <30 days following treatment with intravitreal anti-VEGF therapy (the LAST Study). Eye (Lond). 2012;26:1181-1187.
17. Brown DM, Chen E, Mariani A, Major JC Jr for the SAVE Study Group. Super-dose anti-VEGF (SAVE) trial: 2.0 mg intravitreal ranibizumab for recalcitrant neovascular macular degeneration-primary end point. Ophthalmology. 2013;120:349-354.
18. Stewart MW, Rosenfeld PJ, Penha FM, et al. Pharmacokinetic rationale for dosing every 2 weeks versus 4 weeks with intravitreal ranibizumab, bevacizumab, and aflibercept (vascular endothelial growth factor Trap-eye). Retina. 2012;32:434-457.
19. Lumbroso B, Rispoli M, Savastano MC. Longitudinal optical coherence tomography–angiography study of type 2 naive choroidal neovascularization early response after treatment. Retina. 2015;35:2242-2251.
20. Mimouni M, Meshi A, Vainer I, et al. Bevacizumab dosing every 2 weeks for neovascular age-related macular degeneration refractory to monthly dosing. Jpn J Ophthalmol. 2018;62:652-658.
21. Witkin AJ, Rayess N, Garg SJ, et al. Alternating bi-weekly intravitreal ranibizumab and bevacizumab for refractory neovascular age-related macular degeneration with pigment epithelial detachment. Semin Ophthalmol. 2017;32:309-315.